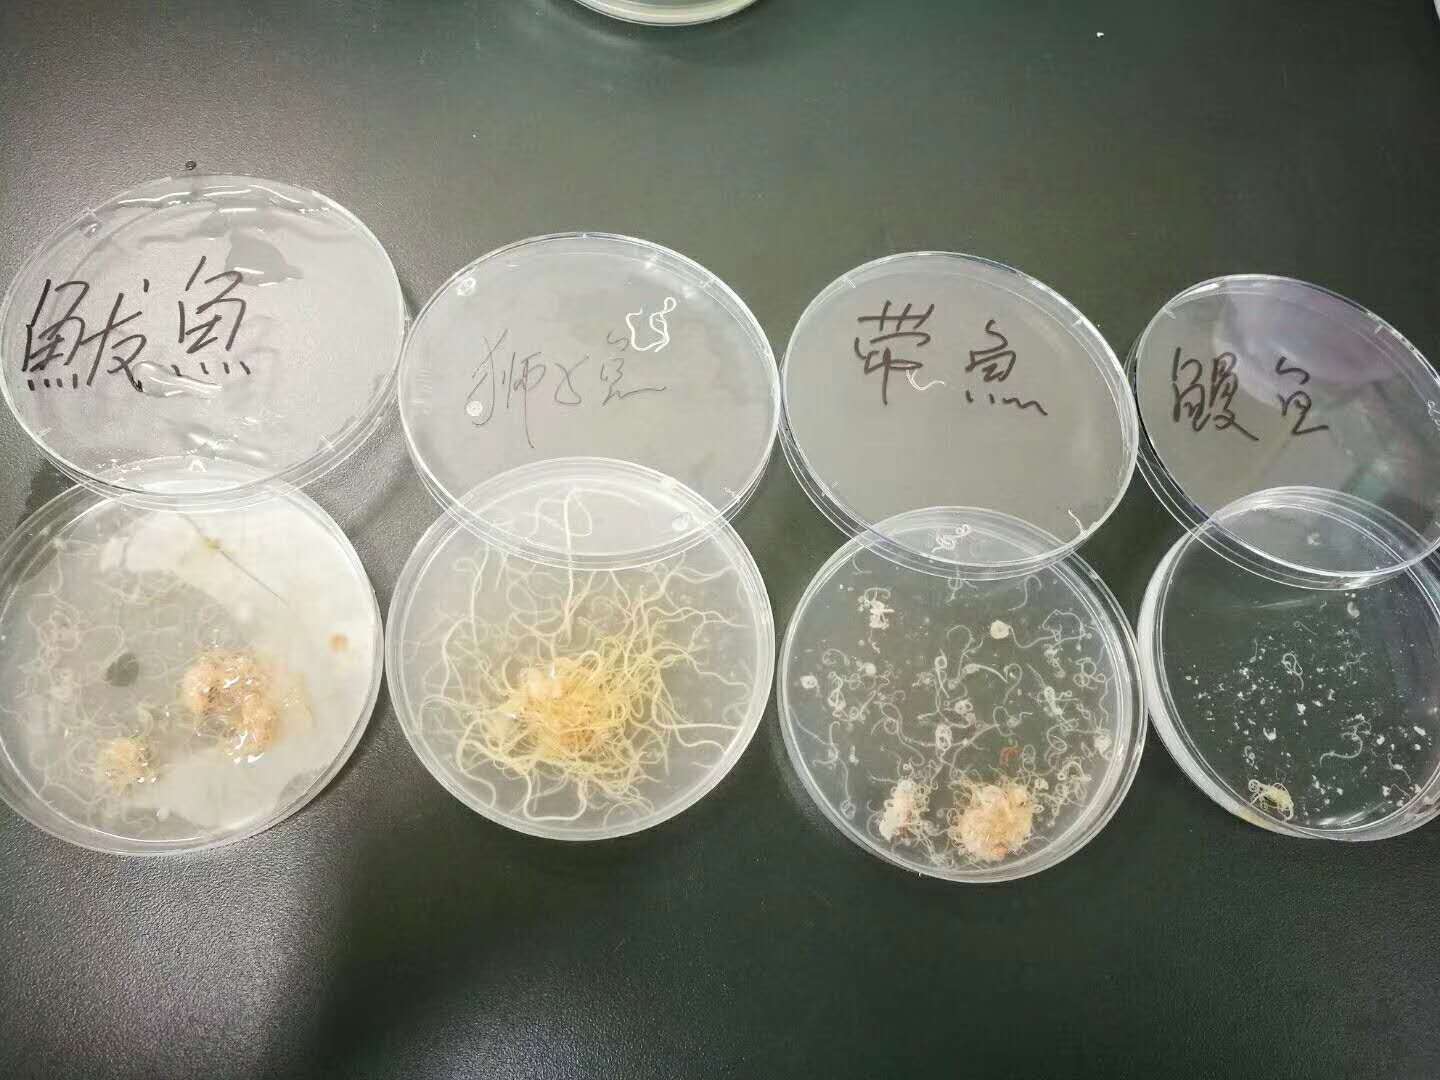

鲅鱼、鲳鱼、八带含异尖线虫,不煮熟敢吃吗?
2017年12月27日 15:20:02
来源:齐鲁壹点
原标题:鲅鱼、鲳鱼、八带含异尖线虫,不煮熟敢吃吗? 我们日常吃的鲅鱼、八带等胃肠道、肝脾大多含异尖线
原标题:鲅鱼、鲳鱼、八带含异尖线虫,不煮熟敢吃吗?
我们日常吃的鲅鱼、八带等胃肠道、肝脾大多含异尖线虫您知道吗?12月27日,崂山区疾病预防控制中心对鲳鱼、沙丁鱼等22种鱼进行了检测,发现除黄花鱼外,其他21种均检出异尖线虫,鱼种检出率95.5%;共检测188条鱼,102条鱼检出异尖线虫,检出率为54.3%。
异尖线虫是一种主要寄生于海洋动物中的蛔目异尖科线虫,其成虫寄生于海栖哺乳动物如鲸、海豚、海狮、海豹的胃部,幼虫寄生于某些海栖鱼类和海产软体动物。人由于食用生的或未煮熟的含有异尖线虫III期幼虫的海鱼或海产软体动物而感染异尖线虫病。该病对人类健康的影响主要是两方面:破坏消化道和导致过敏。由于异尖线虫可在消化道内移行,甚至钻入消化道内壁黏膜,造成消化道严重损坏,表现为恶心、腹痛、呕吐等症状。异尖线虫虫体及其分泌物会引发人体的过敏反应,具体症状为:水肿、风疹、呼吸障碍、甚至休克。
27日一早,疾控中心在市场上购买了22种鱼类,包括鲳鱼、沙丁鱼、大头鯹,黄鱼,八带,石甲鱼,鸦片鱼,鮟鱇鱼,红头鱼,鳗鱼,白姑鱼,鲽小偏口,鳙鱼,狮子鱼,带鱼,鲅鱼,黄花鱼,鮻鱼,古眼鱼,面包鱼,鲈鱼,逛鱼。除黄花鱼外,其他21种均检出异尖线虫,鱼种检出率95.5%。共检测188条鱼,102条鱼检出异尖线虫,检出率为54.3%。
异尖线虫检出部位以胃肠道、肝脾为主,偶见肌肉,是一种长约0.5-3厘米、直径0.5-1毫米的半透亮白色线虫,一端尖细,一端较钝。专家介绍,异尖线虫在鱼、虾等软体类和节肢类水产品中存在较多,但是壳类的像蛤蜊、扇贝、海蛎子等以及三文鱼、金枪鱼等生鱼片中目前未检测出。目前,疾控中心正在检测不同季节、不同温度下对异尖线虫的影响。“假设人们已经食用了含有异尖线虫的鱼,会不会对人体有影响呢?专家表示,一般而言,胃是强酸性环境,可将线虫杀死,同时线虫也是种蛋白,胃、胰蛋白酶也会将线虫融掉,不过并不代表可以食用。日常生活中烹调鱼类时,一定要抛除内脏、充分煮熟,不吃生的或者半生鱼类;同时生熟砧板要分开,避免交叉污染,避免感染异尖线虫病。



凤凰资讯官方微信
视频
-

李咏珍贵私人照曝光:24岁结婚照甜蜜青涩
播放数:145391
-

金庸去世享年94岁,三版“小龙女”李若彤刘亦菲陈妍希悼念
播放数:3277
-

章泽天棒球写真旧照曝光 穿清华校服肤白貌美嫩出水
播放数:143449
-

老年痴呆男子走失10天 在离家1公里工地与工人同住
播放数:165128

























